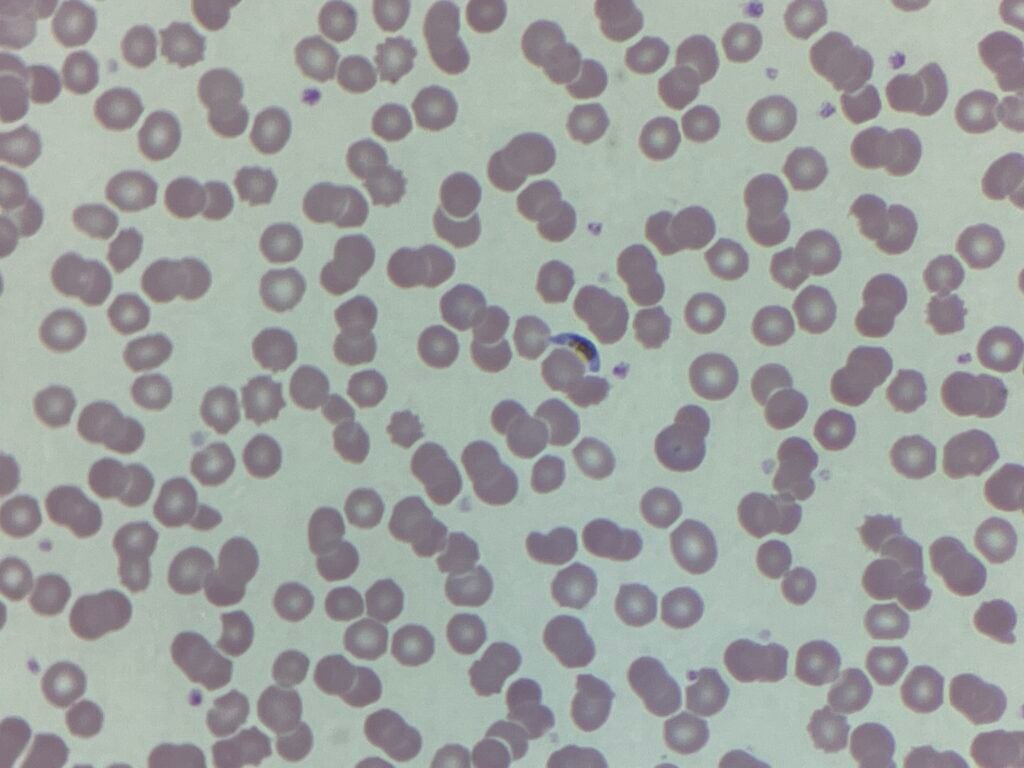
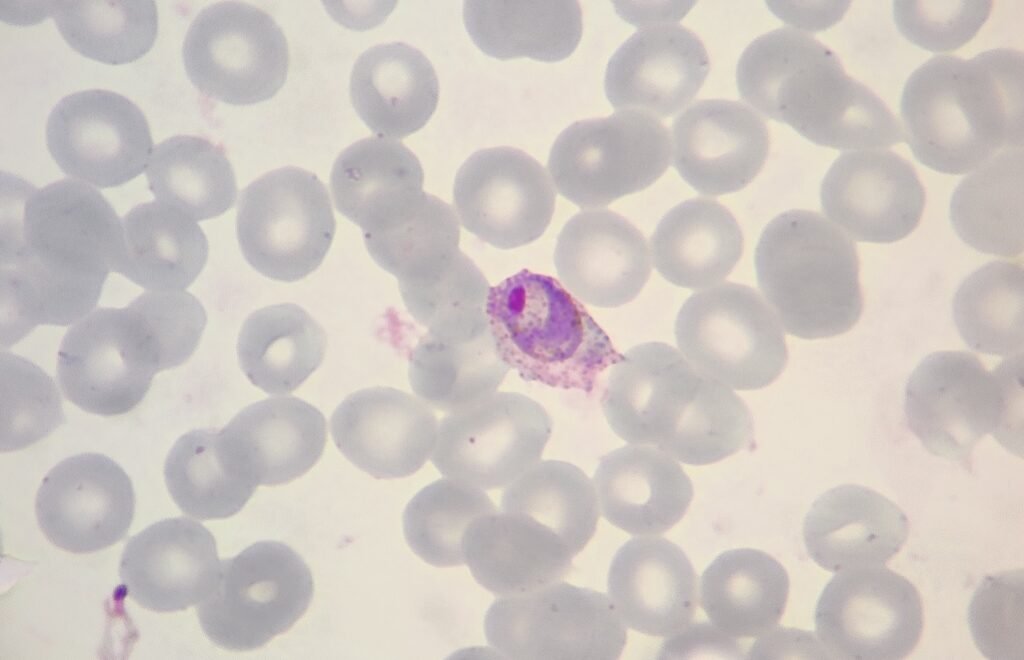

Today, April 25th, marks World Malaria Day, a global reminder that despite decades of progress, malaria remains a deadly and preventable disease. It actually originated from the Africa Malaria Day, which had been observed annually since 2001 by African governments. Recognising the global burden of this disease, the World Health Organization (WHO) then proposed its expansion to become World Malaria Day during the 60th session of the World Health Assembly in 2007.
As a biomedical scientist, I see firsthand the importance of accurate diagnosis and timely treatment. Malaria disproportionately affects children under five and pregnant women, especially in sub-Saharan Africa. Each test I do and every blood film I examine is a chance to break a cycle of suffering, and it reinforces why this day matters.

World Malaria Day isn’t just about awareness – it’s about action. Its core aims are to highlight progress, mobilise resources, and promote research and innovation in diagnostics, treatments, and prevention.
What can you do? Support organisations funding insecticide-treated nets, testing kits, and vaccines. Raise awareness. If you’re in a position to advocate for global health equity—do it. Malaria is preventable. It’s curable. And with global solidarity and science, it’s a disease we can eliminate.
Let’s not forget: health is a shared responsibility.
_____
Images from personal photography.